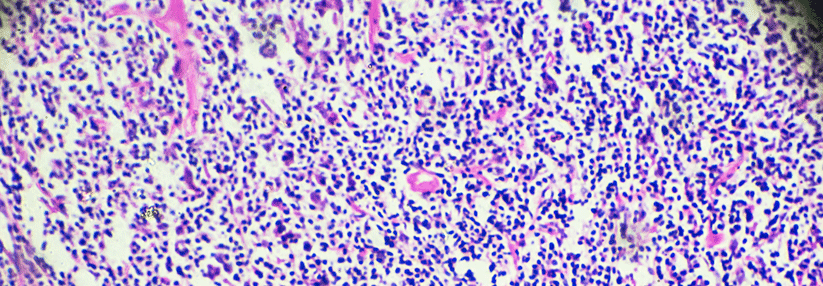

Checkpoint-Blockade beim metastasierten Analkarzinom vielversprechend
 Invasive Analkarzinome werden durch die HPV-Proteine E6 und E7 getriggert.
© fotolia/Kateryna_Kon
Invasive Analkarzinome werden durch die HPV-Proteine E6 und E7 getriggert.
© fotolia/Kateryna_Kon
Plattenepithelkarzinome des Analkanals sind selten – mit allerdings weltweit steigender Inzidenz. Durch eine Chemoradiotherapie sind die Tumoren in aller Regel heilbar, solange sie lokal begrenzt sind. Jeder vierte Patient entwickelt aber Fernmetastasen. Für dieses Stadium der Krankheit gibt es bislang keine allgemein akzeptierte Therapie. Eine neue Option, insbesondere bei HPV-assoziierten Tumoren könnten PD-1-Inhibitoren sein.
In zehn Zentren in den USA wurden daher für diese einarmige Phase-II-Studie insgesamt 37 Patienten mit therapierefraktärem, metastasiertem Plattenepithelkarzinom des Anus rekrutiert und mit dem PD-1-Inhibitor Nivolumab in einer Dosierung von 3 mg/kg alle zwei…
Bitte geben Sie Ihren Benutzernamen und Ihr Passwort ein, um sich an der Website anzumelden.